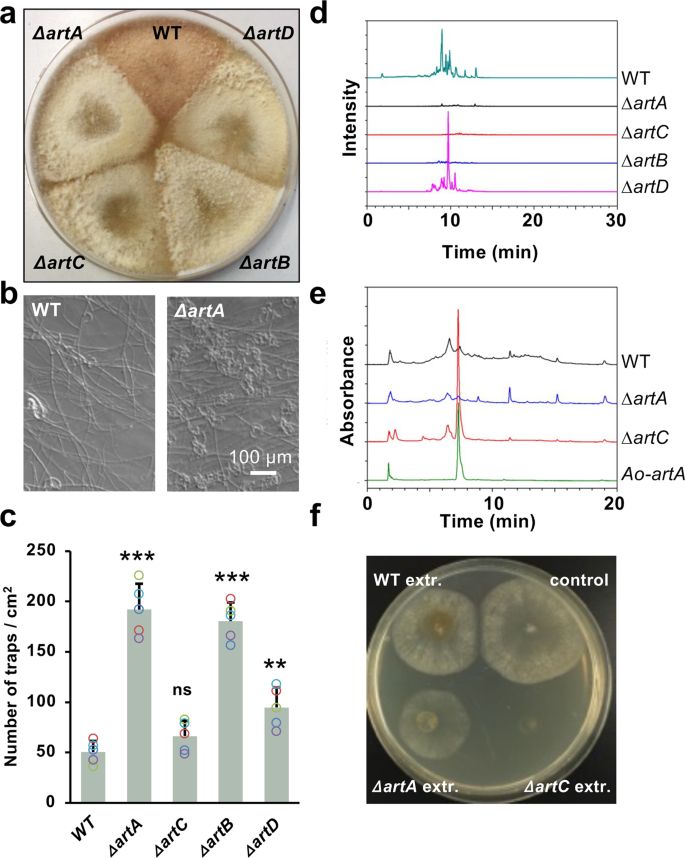
Fig. 1: The artA gene cluster is required for 6-MSA and arthrosporol biosynthesis.

Abstract
Salicylic acid is a phenolic phytohormone which controls plant growth and development. A methyl ester (MSA) derivative thereof is volatile and involved in plant-insect or plant-plant communication. Here we show that the nematode-trapping fungus Duddingtonia flagrans uses a methyl-salicylic acid isomer, 6-MSA as morphogen for spatiotemporal control of trap formation and as chemoattractant to lure Caenorhabditis elegans into fungal colonies. 6-MSA is the product of a polyketide synthase and an intermediate in the biosynthesis of arthrosporols. The polyketide synthase (ArtA), produces 6-MSA in hyphal tips, and is uncoupled from other enzymes required for the conversion of 6-MSA to arthrosporols, which are produced in older hyphae. 6-MSA and arthrosporols both block trap formation. The presence of nematodes inhibits 6-MSA and arthrosporol biosyntheses and thereby enables trap formation. 6-MSA and arthrosporols are thus morphogens with some functions similar to quorum-sensing molecules. We show that 6-MSA is important in interkingdom communication between fungi and nematodes.
Similar content being viewed by others
Introduction
Eukaryotic developmental processes depend on an interplay between internal and external signals which together may lead to massive reprogramming of certain cells. A well-accepted concept in developmental biology is the regulation through gradients of active signaling compounds, called morphogens. Such factors can be transcriptional regulators such as bicoid in Drosophila or extracellular signals1,2.
Filamentous fungi are rather simple organisms with clearly defined developmental pathways to produce different cell types and structures. One well-studied example is the model fungus Aspergillus nidulans which produces asexual and sexual reproductive structures3. Developmental processes are regulated by external stimuli, e.g., light and depend on complicated genetic programs4. There is also evidence for endogenous low-molecular weight compounds which may be involved in the spatial regulation of development. The factors are called PSI factors (precocious sexual inducer) and are oxylipin derivatives5,6. Several A. nidulans enzymes required for the production of the PSI factors have been identified7,8. If secreted chemicals are involved in developmental decisions, they are potential targets for other organisms to interfere or change the normal developmental program.
Low-molecular weight compounds were also discovered in nematode-trapping fungi (NTF) interaction9,10. This group of fungi can switch between saprotrophic growth and a predatory lifestyle11. One of the best-studied examples is the ascomycete Arthrobotrys oligospora and the interaction with Caenorhabditis elegans12,13. The fungus reproduces with asexual conidiospores and, upon starvation and the presence of nematodes, three-dimensional, adhesive trapping networks are formed14,15,16. Low-molecular weight compounds play important roles in the fungal-worm interaction, where A. oligospora responds to C. elegans-derived ascarosides10. Ascarosides are composed of a dideoxy sugar and a fatty-acid like molecule and are important worm signaling molecules17,18. On the other hand, A. oligospora produces several volatile compounds to lure nematodes into the traps. These volatiles were identified as 2-methyl-1-butanol, 2,4-dithiapentane, methyl 3-methyl-2-butenoate, and S-methyl thioacetate9. Not only ascarosides induce the developmental program of trap formation, but also urea. With this compound some bacteria can induce trap formation in the fungus, which then is able to catch the bacterial enemies, the nematodes19.
Whereas the described signaling processes that are important for the organismal interactions, other low-molecular weight compounds, which control development, are arthrosporols20. Arthrosporols are sesquiterpenol derivatives combined with an epoxy cyclohexanol moiety (SEC). Three related molecules have been isolated from A. oligospora, all of which had a negative effect on conidiospore formation, while one stimulated and one reduced the number of traps. The biosynthesis depends on a polyketide synthase, and a corresponding deletion strain produced more traps suggesting a negative role of arthrosporols on trap formation20,21. Sesquiterpenols can thus be considered as morphogens controlling development. The discrepancy between the experiments with the purified compound and the in vivo results with the deletion strain may be explained by the fact that in vivo a blend of different arthrosporols is produced and this mixture represses trap formation. Several other sesquiterpenol derivatives have been described22,23. However, nothing was known so far about concentration gradients, which may trigger different developmental decisions or the modulation of morphogen production or action in response to C. elegans. If C. elegans is present, and the mycelium starved, traps should be formed. Hence, trap formation is regulated by the nutritional status of the mycelium, the developmental competence of the hyphae, and the presence of nematodes.
Here, we analyzed arthrosporol formation in D. flagrans, a fungus closely related to A. oligospora. As a difference to A. oligospora, D. flagrans is able to produce resistant chlamydospores in addition to conidiospores. Chlamydospores are able to pass through the intestinal tract of animals and have therefore been used as biocontrol agents in animal farming (https://www.duddingtonia.com)24. We studied trap formation at the molecular and cellular level and found that the spatiotemporal differential expression of the arthrosporol producing polyketide synthase and the tailoring enzymes lead to 6-methyl salicylic acid and to arthrosporol. Both compounds inhibit trap formation, and C. elegans blocks the production of the inhibitors and thereby induces trap formation. In addition, 6-methyl salicylic acid is a chemical attractant to lure nematodes into the fungal mycelium.
Results
Arthrosporols control trap formation in D. flagrans
The genome of D. flagrans encodes three different polyketide synthases15, one of which with high similarity to a polyketide synthase from A. oligospora where it is involved in trap formation20,21. In order to explore the regulation of this morphogenetic pathway in D. flagrans, we studied the corresponding polyketide synthase gene cluster and named the genes artA-artE (arthrosporol), with artA encoding the synthase (Supplementary Fig. S1a). artA-E gene expression was determined with quantitative real-time PCR using mycelia of D. flagrans cultured in liquid medium. Expression started after two days of growth and increased steadily over time. The putative transcription factor gene, artR, was always very low expressed. Three adjacent genes were poorly expressed and probably do not belong to the cluster (Supplementary Fig. S1b).
To decipher the roles of the putative artA-cluster genes, artA-D were deleted (Supplementary Figs. S2, 3). Whereas wild-type colonies appeared brownish, ∆artA, B, C, and D appeared pale, suggesting a role in pigment formation (Fig. 1a). Next, we studied the effect on trap formation. Wild type produced about 53 traps/cm2 whereas the ΔartA-deletion strain produced ca. 200 traps/cm2 (Fig. 1b, c). In comparison, the ΔartB strain produced 183 and the ΔartD-deletion mutant 95 traps/cm2. The ΔartC-deletion mutant produced similar numbers of traps as wild type. The artA-deletion strain was re-complemented (strain SXD05) with a wild-type copy of artA. In this strain, the trap number was again reduced to the wild-type level (Supplementary Fig. S2c).
a Comparison of colonies of wild-type (WT), a ΔartA- (strain SXY05), a ΔartB- (strain SXY15), a ΔartC- (strain SXY14), and a ΔartD-deletion strain (strain SXY16) after 8 days of growth on PDA agar plates. b Trap formation in WT and the ∆artA-deletion strain (scale bar, 100 µm). c Quantification of traps induced by the same number of C. elegans N2 in D. flagrans strains as indicated (mean ± SD, n = 5 biological with 3 technical replicates; asterisks represent significance levels as determined with the unpaired t-test compared to WT; *p < 0.05, **p < 0.01, ***p < 0.001; ΔartA p-value = 3.36858E-06, ΔartB p = 0.097611834; ΔartC p = 9.20668E-07, ΔartD p = 0.002468371). d HPLC-DAD profiles of the extracts of the strains indicated. e LC–MS/MS quantification of 6-MSA from culture extracts of the strains indicated. Ao-artA (strain SXD01) means A. oryzae expressing artA. f Inhibition of D. flagrans by extracts of different strains. D. flagrans was point inoculated and 30 µl of the metabolite extracts added. The plate was incubated for 3 days at 28 °C. Source data are provided as a Source Data file.
In order to elucidate the artA-cluster biosynthetic pathway, we analyzed the culture broths of WT and the ΔartA-D deletion strains by high-performance liquid chromatography (HPLC−DAD) and high-resolution LC–MS. Arthrosporol A-C were produced in wild type (monoisotopic mass of 410.2305, A, B and C, Supplementary Fig. S4) and were absent in the ∆artA, ∆artB, or the ∆artC-deletion strains (Fig. 1d). The production of arthrosporols was normal in the ∆artD-deletion strain. These results suggest that only artA, artB, and artC are involved in the biosynthesis of arthrosporol A-C (Supplementary Fig. S4), and artD is required for pigment biosynthesis. In the ∆artB-deletion strain m-cresol (Supplementary Fig. S5), and in the ΔartC-deletion strain 6-MSA accumulated, suggesting that 6-MSA is the direct product of ArtA. 6-MSA concentrations were calculated from peak areas in the HPLC profile using 6-MSA standard solutions for calibration. The artC-deletion strain produced about 6000 times more 6-MSA than wild type. The fact that 6-MSA was also detected in wild type, suggests that small amounts are produced under natural conditions in the presence of all enzymes. 6-MSA production by ArtA was proven by heterologous expression of ArtA in Aspergillus oryzae (strain SXD01) (Fig. 1e, Supplementary Fig. S7)25. The obtained results led us to propose a shared biosynthetic pathway for arthrosporols and pigments in D. flagrans (Fig. 2a), which is in agreement with the proposed pathway in A. oligospora21,26.
a Proposed pathway for the biosynthesis of 6-MSA, arthrosporols and pigment. Some intermediates were determined in this study (green arrow) and some were deduced from the work in A. oligospora (grey arrow). b The promoter of artA was fused to h2b and mCherry (strain SXY17) and different hyphal structures were analyzed. Spatiotemporal control of artA and artB (strain SXY20) expression in vegetative hyphal tips, aerial hyphal tips (old hyphae), new traps, old traps, and conidia. c ArtA-GFP and ArtB-mCherry co-expression after integration of the tagging constructs in locus (strain SXD53). The scale bars represent 10 µm.
Next, we tested the effect of extracts of wild type and the different deletion strains on growth and trap formation and found that extracts of the ∆artC-deletion strain severely reduced hyphal growth (Fig. 1f, Supplementary Fig. S6a). In addition, conidia and chlamydospores rarely germinated even after several days of cultivation. Diluted extracts of the ∆artC-deletion strain lowered the germination ratio of spores and led to unhealthy hyphae (Supplementary Fig. S6a). The same effects were observed with extracts from the A. oryzae artA-expressing strain suggesting that 6-MSA also inhibits trap formation. In addition, germination of spores was blocked, and trap formation gradually inhibited with increasing concentrations of 6-MSA (Supplementary Fig. S6b, c). Extracts of a D. flagrans ∆artC-deletion strain also inhibited growth of Alternaria alternata, whereas extracts of a ∆artA-deletion strain did not, showing the broad action of 6-MSA on fungi (Supplementary Fig. S6d).
The artA gene cluster genes are differentially expressed in time and space
The next question was, if the biological activities of arthrosporol and 6-MSA were of any biological meaning. 6-MSA should only be an endogenous intermediate and quickly converted to arthrosporols if all enzymes were expressed (Fig. 2a). In addition, if arthrosporols inhibit trap formation, but are produced early during hyphal growth, the question raises, if and how nematodes may interfere with the production of arthrosporols. Quantitative real-time PCR analyses revealed an increase of transcript abundance with time, but these experiments did not allow any spatial resolution (Supplementary Fig. S1b). Therefore, we developed an assay to monitor the expression of the artA-C genes in time and space. To this end, the promoter of the gene of interest was fused with the h2b (histone 2 b) gene and with mCherry. If a promoter is active, the fusion protein should be concentrated in nuclei. This is very easily distinguished from possible autofluorescence of older hyphae and should be easy to quantify. For artA, the strongest fluorescent signals were found in the nuclei in hyphal tips (Fig. 2b). To show that the accumulated fluorescent proteins reflect continuous, active transcription and translation, we bleached the hyphae and observed recovery after 14 min (Supplementary Fig. S8). A similar reporter construct was constructed for artB and artC (Fig. 2b, Supplementary Fig. S9). In contrast to artA, no fluorescent signal was obtained in hyphal tips and young hyphae. However, in older substrate- and arial hyphae, which are produced after some time, fluorescent signals were obtained for the artA- and the artB, C reporter. When trap formation was induced after addition of C. elegans, fluorescence for artA-C was not detected in newly formed but in older traps and in conidia and chlamydospores (Fig. 2b, Supplementary Fig. S9). These results suggest different spatially and timely regulated promoter activities for artA and artB, C.
To confirm the observed expression pattern obtained with the promoter-reporter construct and analyze if protein expression follows the same pattern, we tagged ArtA C-terminally with GFP and ArtB with mCherry in locus in the same strain. The constructs were integrated into the D. flagrans genome by homologous recombination and fluorescence detected in young hyphal tips, older substrate-, and aerial hyphae. The fluorescent signal of ArtA was strong in hyphal tips, whereas the signal for ArtB was almost undetectable (Fig. 2c). Older hyphae, spores, and older traps were highly fluorescent for both ArtA and ArtB (Fig. 2c).
When observing longer hyphae of the above transcription-reporter strains, we noticed interesting expression gradients. Whereas artA expression decreased from the tip to the rear of the hyphae, the fluorescent signals of the artB and artC constructs were very weak in hyphal tips and young traps and appeared very strong in old hyphal parts and spores (Fig. 3). These results indicate strict spatiotemporal control of different genes of the artA-gene cluster and hence probably the production of 6-MSA in hyphal tips and the production of arthrosporols in older hyphae and older traps. Our results suggest that the artA-gene cluster is responsible for the production of pigments, arthrosporols, and 6-MSA. To our knowledge, this is the first example that the biosynthetic capacity of a secondary metabolite gene cluster is increased by temporal and spatial regulation of certain cluster genes.
a Visualization of expression gradients of art A (strain SXY17), artB (strain SXY20), and artC (strain SXY19) along a hypha. Scale bar, 20 µm. b Quantification of CTCF intensity values of nuclei in hyphae displayed in a. (Mean ± SD; n = 10 biologically independent samples.) Source data are provided as a Source Data file.
C. elegans ascarosides regulate arthrosporol and 6-MSA biosynthesis
We showed that the D. flagrans mycelium produces arthrosporols and 6-MSA and both compounds inhibit trap formation. This raises the question how trap formation is induced in the presence of nematodes. To test the hypothesis that the presence of C. elegans causes repression of the production of the inhibitors arthrosporol and 6-MSA, we added C. elegans to growing mycelium of D. flagrans on low nutrient medium and studied the expression of artA-D by quantitative real-time PCR before adding the worms and 6 and 24 h after addition of the nematodes (Fig. 4a). In all four cases (artA-D), transcript abundances were reduced after 6 h and recovered slightly after 24 h. The expression levels varied to some extent between biological replicates. This may be due to variations of the number of traps, and the fact that the mycelium does not express the genes homogenously in all hyphae (see above). Therefore, we analyzed gene expression also at the cellular level using the established reporter construct for artA (Fig. 4b). Hyphal tips indeed did not show fluorescence in the presence of worms. The next question was how the presence of worms may affect the artA expression level. Because C. elegans ascarosides have been shown to induce trap formation in A. oligospora, we anticipated that these molecules could directly act on artA-gene expression10. As a first step to confirm this hypothesis, we applied the supernatant of a water solution washed off from culture plates of C. elegans (= worm water) to hyphae and observed the same downregulation of artA. Next, we followed a protocol for ascaroside extraction and could also show the effect with the crude ascaroside fraction (Fig. 4b).
a Expression levels of four genes of the artA cluster (artA, artB, artC, and artD) were repressed after addition of C. elegans. D. flagrans spores were germinated on cellophane paper on LNA medium and grown overnight at 28 °C. Then seven-day-old cultured nematodes (about 50,000) were added and mycelia harvested at the times indicated and processed for quantitative real-time RT PCR analysis (mean ± SD, n = 3 biological with 3 technical replicates; asterisks represent significance levels as determined with the unpaired t test compared to WT; *p < 0.05, artA 0 h vs 6 h, p-value = 0.025; artB 0 h vs 6 h, p-value = 0.027; artC 0 h vs 6 h, p-value = 0.030; artD 0 h vs 6 h, p-value = 0.020). b Scheme of the ascaroside blend isolation (left, pictures were used from the ChemDraw software package). Microscopic visualization of the expression of artA (strain SXY17) after treatment with worms or the ascarosides blend in hyphal tips (right). Scale bar, 20 µm. Source data are provided as a Source Data file.
6-MSA as chemoattractant for C. elegans
The spatial expression patterns of artA-C suggested the production of 6-MSA at hyphal tips and the production of arthrosporols further back and in older hyphae and traps. Both compounds inhibit trap formation, and 6-MSA also inhibited germination and hyphal extension. However, the question was if 6-MSA could play an additional role at hyphal tips. Another salicylic acid derivative, its methyl ester (MSA), also known as wintergreen oil, is a well-known signaling compound in plant–pathogen interactions27,28. Plants under herbivore attack may use MSA to attract enemies of the herbivores29. It was also shown that such volatiles may indicate putative host plant roots for herbivores like root-knot nematodes30. Therefore, we tested if 6-MSA could be involved in the fungal–nematode interaction (Fig. 5). We first tested the WT and the ∆artA-deletion strain in a chemotaxis assay. Wild-type colonies clearly attracted C. elegans independent if the mycelium was growing on the same agar medium as the nematodes or if the mycelium was placed in the center of a lid of a petri dish and the nematodes on the bottom (Fig. 5a, b). These results showed that D. flagrans produces volatile compounds to attract C. elegans. In the artA-deletion strain, the effect was reduced, suggesting that 6-MSA could be a chemoattractant. The remaining response was probably due to other compounds such as MMB (methyl-3-methyl-2 butenoate)9. To further test this hypothesis, we applied 6-MSA directly in the chemotaxis assay and found that it is active as chemoattractant (Fig. 5c). However, rather high concentrations were required for the effect, which may be due to the fact, that the chemical was mixed in a liquid agar sample and then applied to a side of the agar plate. To simulate a more natural situation, we tested the A. oryzae strain producing 6-MSA in the chemotaxis assay. Whereas the A. oryzae strain containing an empty vector, was not attractive for C. elegans, expression of artA made the strain attractive (Fig. 5d).
a Four-point chemotaxis assay with direct physical contact of mycelia and worms. The chemotaxis index was calculated from 4 to 10 experiments. Three biological replicates. b Headspace chemotaxis assay. The fungal strains were grown in the lid of a petri dish and the nematodes in the bottom. c Chemotaxis assay with 6-MSA on agar plates. Nematodes were initially placed in the center of the plate. In all three assays, a score of 100% represents maximum attraction. Assays for each condition were repeated at least six times on at least two different days. d Chemotaxis assay with A. oryzae (transformed with empty vector) or A. oryzae expressing artA. Nematodes were initially placed in the center of the plate. Y-axis represents the induced fold of worms’ number, compared with the A. oryzae control (set as a score of 1, n = 10). Data were expressed as mean ± SD. The error bar represents the standard deviation. Asterisks represent significance levels as determined with the unpaired t-test compared to WT; *p < 0.05, **p < 0.01, ***p < 0.001. a p-value = 0.031290533; b p-value = 0.013388722; d p-value = 5.57371E-08. Source data are provided as a Source Data file.
Discussion
The interaction between nematodes and nematode-trapping fungi requires sophisticated inter-organismic communication with low-molecular weight signaling molecules. C. elegans produces a blend of different ascarosides, normally used for male attraction and other behavioral controls as well as developmental decisions18. On the other hand, the fungal counterpart produces various volatile compounds to lure nematodes into the traps9. In addition, the fungi produce a number of different sequiterpenyl expoxy-cyclohexenoids (SEC), which control trap formation. At least three arthrosporols, oligosporons, and arthrobotrisin were identified in extracts of A. oligospora20,23. The biosynthesis of these SECs has been studied with targeted gene-deletions followed by metabolome analyses21,22,31. A polyketide synthase is one of the central enzymes. Deletion of this polyketide synthase gene caused an increase of the number of traps, but it remained open if all or only some SECs are involved in the repression of trap formation and if certain intermediates would be important as well21. Here, we showed that the expression of individual genes of the artA-gene cluster are individually regulated in time and space and through the presence of nematodes, resulting in different cocktails of low-molecular weight compounds with different effects on hyphal development in different parts of the mycelium and dependent on the number of worms. In a colony without any worms the polyketide synthase ArtA is mainly produced at hyphal tips (Fig. 6). Because artB-D are not expressed in hyphal tips, 6-MSA should accumulate there. This compound prevents trap formation at the tip of the hypha. In the rear of the hypha, artA is expressed along with artB and C, leading to the production of arthrosporols, which also inhibit trap formation. If nematodes are added to the mycelium, artA is downregulated, thereby inducing trap formation. Young traps also do not express artA and therefore, new traps can be added resulting in trapping networks. However, old traps resume artA-C gene cluster expression and limit further trap development. If both, arthrosporols and 6-MSA inhibit trap formation, the question arises why the two compounds are required and why they are produced in different parts of the mycelium. One explanation could be the fact that 6-MSA has nematicidal activity26. This means that the hyphal tips, which are at the forefront of the growing mycelium and are the first ones with contact to nematodes, can act on nematodes and perhaps facilitate the trapping process. On the other hand, we found that 6-MSA attracts C. elegans and lures the worms into the mycelium.
Gradients of 6-MSA, arthrosporols, and ascarosides control trap formation in D. flagrans. 6-MSA is produced at hyphal tips, while further back 6-MSA is converted to arthrosporols. Both compounds block trap formation. After successful attraction of a large number of nematodes by 6-MSA and other molecules, the concentration of ascarosides raises above a threshold. This will result in the downregulation of the artA-gene cluster genes, which in turn causes a decrease of 6-MSA and arthrosporols. If their concentration falls below a threshold, repression of trap formation is released, and traps are formed to catch the worms. After the digestion of trapped worms (red color), artA-gene cluster gene expression resumes, and increasing arthrosporols concentrations prevent unnecessary and excessive trap formation. Bigger font size symbolizes higher expression levels.
The control of trap formation in D. flagrans is rather complicated and requires the integration of internal signals, such as starvation, with the presence of nematodes. It appears that fungal and nematode-derived low-molecular weight compounds are important for the regulation and the question arises why such a complicated system evolved. Diffusible molecules such as arthrosporols and 6-MSA can be produced within a colony and that way block trap formation in the entire mycelium. If now only one nematode moves across a colony, the nematode-derived ascarosides will downregulate the art genes in the hyphae in the vicinity of the worm. If this would lead to the induction of traps, several hours later mature traps would be ready, but then of course the nematode would be gone. Trap formation only makes sense in the presence of many nematodes. High numbers of nematodes will lead to high concentrations of ascarosides, which in turn will downregulate arthrosporol and 6-MSA formation in the entire colony. Hence traps will be formed in the entire colony. Therefore, arthrosporols/6-MSA and ascarosides can also be considered as quorum-sensing molecules.
Our work emphasizes the importance of methylated isoforms of salicylic acid as signaling molecules. Whereas the unmethylated form is used as plant hormone, the methylated volatile forms are important for long-distance communication27,29,32. It is noteworthy that the chemical origin of the molecules is very different. Whereas plants produce SA and MSA (the methyl ester) from cinnamic acid, a product of the shikimate pathway, fungal 6-MSA is the result of a polyketide synthase33. Hence, the two isoforms are examples for molecules with similar signaling functions but very different evolutionary origins.
Methods
Strains and culture conditions
D. flagrans (CBS 349.94) was obtained from the CBS-KNAW culture collection (The Netherlands). D. flagrans and C. elegans were cultured as described15 (http://www.wormbook.org). Unless otherwise specified, PDA (potato-dextrose-agar, Sigma) and PDB (potato-dextrose broth) were used as media for routine growth of the fungus. The liquid culture was shaken at 180 rpm, 28°C under standard indoor light conditions. A modified low nutrient-agar (LNA)1 (KCl 1 g/l, MgSO4 - 7H2O 0.2 g, MnSO4 - 4H2O 0.4 mg, ZnSO4 - 7H2O 0.88 mg, FeCl3 - 6H2O, 3 mg, Agar 10 g, pH 5.5) was used for the induction of trap formation and microscopy. All strains are listed in Table S1, oligonucleotides in Table S2, and plasmids in Table S3.
RNA isolation and quantitative real-time PCR
Method 1 without worms: The same amounts of spores of different fungal strains were inoculated in liquid PDB medium in 3.5 cm petri dishes and cultivated for 2, 3, 4, and 6 days. The mycelium was harvested directly and frozen immediately in liquid nitrogen. Method 2 with worms: 106 spores of wild type were inoculated on cellophane on the surface of LNA media and cultivated at 28 °C overnight. On the second day 7-day-cultured nematodes were washed off with DEPC water and added to the fungus. After 0, 6, and 24 h the induced mycelium was harvested from the cellophane paper and frozen immediately in liquid nitrogen. Total RNA was extracted with E.Z.N.A.® Tissue DNA Kit from Omega (Norcross, Georgia). DNase digestion was performed using the TURBO DNA-free kit (Thermo Fisher; Waltham, Massachusetts) and the RNA was diluted to 50 ng/μl with DEPC water. Quantitative real-time PCR was performed with SensiFAST SYBR and a Fluorescein One-Step Kit from Bioline (Lueckenwalde, Germany) on a CFX Connect Real-Time PCR Detection System (Bio-Rad, Munich, Germany). Each reaction had a volume of 25 μl with 0.2 μM primers and 100 ng RNA according to the protocol of the kit. The program and melting curve analyses were carried out as described15,34. Fold changes were calculated using the formula 2−(ΔΔCt). The gamma actin orthologue DFL_002353 was used as an internal reference gene for normalization. The qRT-PCR was performed using three biological replicates. Oligonucleotides used for real-time PCR are listed in Table S3.
Plasmid construction
To create a C-terminal mCherry fusion of histone H2B under the control of different promoters, the related fragment including the promoter sequences were amplified by PCR, using D. flagrans genomic DNA as template (artA promoter: 1407 bp, amplified with primers artA(p)-h2b-fw and artA (p)-h2b-rev; artB promoter: 1141 bp, amplified with primers artB(p)-h2b-fw and artB(p)-h2b-rev; artC promoter: 1567 bp, amplified with primers artC(p)-h2b-fw and artC(p)-h2b-rev). The backbone of the plasmid containing the mCherry was amplified and assembled with the promoter fragment using the NEBuilder HiFi DNA Assembly Cloning Kit (New England Biolabs, Frankfurt). Q5 High-Fidelity DNA polymerase for PCR and restriction enzymes were purchased from New England Biolabs (Frankfurt, Germany).
The artA-cluster genes were deleted by homologous recombination. Around 1 kb flanks homologous to the 5′ and 3′ regions of the targeted gene were amplified by PCR, using D. flagrans genomic DNA as template (artA: 856 bp/1039 bp (amplified with primers artA olup_fw and artA olup_rev, artA oldown_fw and artA oldown_rev); artB: 1430 bp/931 bp (amplified with primers artBolup_fw and artBolup_rev, artBoldown_fw and artBoldown_rev); artC: 1141 bp/1067 bp (amplified with primers artColup_fw and artColup_rev, artColdown_fw and artColdown_rev);; artD: 1311 bp/912 bp (amplified with primers artDolup_fw and artDolup_rev, artDoldown_fw and artDoldown_rev)). The hygromycin-B resistance cassette hph was amplified using pFC332 as the template (1835 bp, (amplified with primers hygolup_fw and hygolup_rev)). All fragments for each gene were assembled into the pJET1.2 vector (Thermo Fisher, digested with EcoRV) using the NEBuilder HiFi DNA Assembly Cloning Kit (New England Biolabs, Frankfurt). Phusion polymerase (NEB) was used for PCR and the fragments contained 25 bp overlapping regions to the neighboring fragment. Standard transformation procedure and plasmid isolation for Escherichia coli were used.
ArtA and ArtB protein co-localization
The artA and the artB gene were tagged by homologous recombination in the same strain and thereby integrated in locus. About 1 kb flanks homologous to the end of each gene before the stop codon and the 3′ regions of the targeted gene were amplified by PCR, using D. flagrans genomic DNA as template (artA: 956 bp/798 bp (amplified with primers pksAend_pjet_ol_for and pksAend_gfp_ol_rev, pksARB_hph_ol_for and pksARB_pjet_ol_rev); artB: 946 bp/940 bp (amplified with primers ArtBend_pjet_ol_for and ArtBend_mcherry_ol_rev, ArtBRB_H_ol_for and ArtBRB_pjet_ol_rev)). The hygromycin-B resistance cassette hph was amplified using pFC332 as template (1835 bp, (amplified with primers H_Gfp_ol_for and H-pksARB-ol-rev for artA, H_mcherry_ol_for and H_artBRB_ol_rev for artB). The GFP and mCherry cassettes were amplified (780 bp/762 bp, (amplified with primers Gfp_pksAend_ol_for and Gfp_H_ol_rev, Mcherry_artBend_ol_for and Mcherry_H_ol_rev). All fragments for each gene were assembled into the pJET1.2 vector (Thermo Fisher, digested with EcoRV) using the NEBuilder HiFi DNA Assembly Cloning Kit (New England Biolabs, Frankfurt). Phusion polymerase (NEB) was used for PCR and the fragments contained 25 bp overlapping regions to the neighboring fragment. Standard transformation procedure and plasmid isolation for E. coli were used.
Protoplast transformation of D. flagrans
Protoplast transformation and gene targeting in D. flagrans were done as described15. Briefly, after cultivated for 24–36 h at 28˚C, 180 rpm, the mycelium was harvested and washed with MN solution (0.3 mol/l MgSO4, 0.3 mol/l CaCl2), and suspended in 10 ml MN buffer containing 4 mg/ml kitalase (Fujifilm Wako Chemicals) and 20 mg/ml VinoTaste Pro (Novozymes), followed by incubation for 2 h at 30˚C, 70 rpm. Protoplasts were collected by filtering through 3-layers of sterile miracloth tissue and centrifuged for 15 min at 2.400 x g. Protoplasts were washed twice with KTC (1.2 mol/l KCl, 10 mmol/l Tris-HCl pH 7.5) solution and finally resuspended in 700 μl KTC. Protoplasts were quantified using light microscopy. Hundred microliter of protoplasts (5 × 106) were mixed with 5–8 μg of DNA and incubated for 2 min on ice. One milliliter of PTC (50% polyethylene glycol 6000, 20 mM Tris−HCl at pH 7.5, and 50 mM CaCl2) was added and mixed gently. After incubation at room temperature for 20 min, 10 ml PDSSA (24 g/l potato dextrose broth, 0.6 mol/l sucrose, 0.3 g/l peptone, 0.3 g/l tryptone, 0.3 g/l yeast extract, 14 g/l agar) was added to the transformation mixture and then poured onto PDA plates supplemented with 100 μg/ml hygromycin-B. Transformed colonies were selected after incubation at 28 °C for 5−7 days. After single-spore isolation, correct transformants were identified by PCR and Southern blot analyses.
Germination and hyphal growth experiments
To determine pigmentation and hyphal growth, the same amount of spores (1 × 104) of different strains were inoculated at the center of PDA agar plates and incubated at 28˚C. Hyphal growth was calculated by kymograph analysis using the Fiji software (https://fiji.sc). Colonies were photographed every day. An AxioObserver Z1 inverted microscope using a 10x/0.30 N.A. objective (Zeiss) was used to check hyphal growth and spore production.
Trap induction and microscopy
To quantify traps, fungal spores were harvested after 10 days cultivation on PDA agar plates. A total of 1 × 104 spores were transferred to a thin LNA plate, and around 100 individuals of C. elegans were added. Co-incubation was carried out at room temperature in darkness for 24 h at 28˚C. Trap formation was observed and quantified under the microscope. Conventional fluorescence images were captured at room temperature using a Zeiss Plan-Apochromat 63x/1.4 Oil DIC, EC Plan-Neofluar 40x/0.75, EC Plan-Neofluar 20x/0.50, or EC Plan-Neofluar 10x/0.30 objective attached to a Zeiss AxioImager Z.1 and Axio-CamMR. CTCF (Corrected Total Cell Fluorescence) = Integrated Density − (Area of selected cell × Mean fluorescence of background readings). The cell fluorescence was measured using Image J. (https://theolb.readthedocs.io/en/latest/imaging/measuring-cell-fluorescence-using-imagej.html, contributed by Luke Hammond, the University of Queensland, Australia.)
Fluorescence recovery after photobleaching (FRAP) was used to check artA-mCherry expression of the hypha in artA(p)::h2b::mCherry. A total of 1 × 104 spores were plated on thin LNA on coverslips, and C. elegans were added. After co-incubation for 12 h, a hypha was chosen under the microscope, bleached for 5 s and recovery monitored after 14 min (63x/1.4 Oil). FRAP was carried out using a Zeiss LSM 980, according to the Basic User Notes Airyscan.
Inhibition of germination and trap formation by 6-MSA
6-MSA solution was prepared (1 mM) and diluted to different concentrations in DMSO. Solvent was used as control. Fungal spores were harvested after 10 days cultivation on PDA agar plates. A total of 1 × 106 spores were transferred to a thin LNA agar containing different concentrations of 6-MSA (1, 2, 5, 10, and 20 mM) and the numbers of germinated and ungerminated spores were counted under the microscope. The experiment was repeated five times. To quantify the number of traps, 1 × 106 spores were inoculated on a thin LNA plate, incubated for 1 day at 28˚C. On the second day, different amounts of 6-MSA were added to the medium, leading to final concentrations of 222, 250, 286, 333, 400, 500, and 667 µM. Then around 100 individuals of C. elegans were added. Co-incubation was carried out in the dark for 24 h at 28˚C. Traps were quantified under the microscope.
Fermentation and extraction procedures
The same amounts of spores of D. flagrans strains were inoculated into 250 ml flasks containing 100 ml PDB medium and shaken at 180 rpm at 28°C for 8 days. The culture broths were filtered to separate the mycelia from the liquid. The mycelial pellets were extracted with 20 ml ethyl acetate and the supernatant extracted with ethyl acetate (1:1, v/v) for 1 h at room temperature. The organic fractions from the two parts were mixed and evaporated to dryness, then dissolved in 500 μl of methanol, filtered through 0.22 μm membranes, and further analyzed using high-performance liquid chromatography (HPLC−DAD) and gas chromatography−mass spectrometry (GC−MS) or HPLC–MS/MS.
HPLC–DAD analyses
The samples were analyzed by HPLC (Agilent 1100, Waldbronn, Germany). The system was equipped with a Hypersil ODS RP C-18, 3 μm, 4 (i.d.) × 100 mm column (Thermo Fisher Scientific, Karlsruhe, Germany)21. The total flow rate was 1 ml/min with the mobile phase A with 0.1% formic acid in water and the mobile phase B with 0.1% formic acid in acetonitrile. The total running time was 30 min, starting at 10% of eluent A and 90% of eluent B for 2 min, followed by a linear gradient to 90% of eluent A over 18 min, holding for 4 min and back to the starting conditions to equilibrate the column for the next run. The column temperature was maintained at 40 °C. The injection volume for the extracts was 20 μl.
HPLC–HRMS analyses
HPLC–HRMS analysis was carried out according to a modified method35. Mass spectrometric analyses were done using an X500R™ high-resolution ESI-Q-ToF mass spectrometer (Sciex, Toronto, Canada) equipped with an electrospray ionization (ESI) source operating in the positive ion mode as described before25. The HPLC–MS method was used to quantify 6-MSA (method 1). Arthrosporols were analyzed by their representative molecular ions or/and (?) quantitative ions. Automatically performed MS/MS experiments revealed the identity of the compound due to the specific fragmentation patterns (method 2)20. For the characterization of arthrosporols, the parameters were as follows: quantitative ions m/z [M-H]-/fragment ions: 393.1/138.9*, qualitative ions m/z: 121.2/373.2, declustering potential U/V: -29/-29/-29, collision energy U/ev: -13/-28/-13. Nitrogen was used as nebulizer, curtain and collision gas in all the experiments. Data analyses were done using the Origin software.
GC–MS analyses
GC–MS analysis was performed on a GC-2010 Plus system (Shimadzu Corp., Kyoto, Japan) equipped with an DB-5(MS) column (5%-phenyl/95%-methylpolysiloxane; 30 m length x 0.25 mm i.d. x 0.25 µm film thickness; Agilent Technologies, Santa Clara, CA, USA). The initial column temperature of 100 °C was ramped at 5 °C/min up to 300 °C. Helium at a flow rate of 40 cm/s was used as carrier gas with Split injection mode (ratio 1:30). Extracts were dissolved in 1 ml methanol using a sonification bath for 20 min. Samples were centrifuged and the supernatant was used for GC–MS analysis. The injection temperature was 280 °C, the transfer line was held at 300 °C, and electron impact mass spectra were recorded at 70 eV. Peak identification was accomplished via the NIST11 Standards Reference Database integrated with the GC/MS solution software (version 2.72).
Generation of “worm water”
A total of 106 spores of D. flagrans were spread on LNA agar medium and grown for 24 h at 28°C. 7-day-cultured nematodes were washed off with 500 μl water and the suspension was kept at room temperature for 4 h. Then the suspension was centrifuged at 2,400 × g for 10 min and the supernatant (“worm water”) was added to germinated spores. After 24 h the expression levels of the proteins were checked in the microscope.
Ascarosides isolation
For the isolation of a blend of ascarosides, we followed essentially a published protocol36. A total of 90,000 worms were inoculated into 150 ml culture medium and incubated at 20 °C for 9 days with shaking at 225 rpm. The culture was then kept on ice for 30 min to 1 h before the worms were sedimented by centrifugation (19,000 × g, 30 min). The supernatant was freeze-dried, and the dried material dissolved in 20 ml chloroform: methanol (3:1). After evaporation of the solvent, the residual compounds were dissolved in 1 ml ddH2O, centrifuged to remove unsoluble material, and the supernatant freeze-dried a second time. The final material was resuspended in 0.5 ml ddH2O and filtered through a membrane (22 µm pore diameter). The extracted ascaroside blend was added to the targeted samples on the microscopic slides.
Chemotaxis assays
Chemotaxis assays were performed on 9 cm petri dishes containing LNA medium. Method 1: Direct contact bioassay: The same amount of spores were inoculated on LNA medium (1 × 106 spores/μl) for 36 h, then about 300 nematodes were added to the center of the plates. To minimize the effects of adaptation, sodium azide (an anesthetic) was used to immobilize animals at the attractant and control areas. The attracted worms on four sections were counted after 4 h. The chemotaxis index was calculated as described (the number of animals on sample quadrants minus the number of animals on control quadrants)/(total number of animals)9. Method 2: Non-direct contact bioassay: Fungal strains and the nematodes shared the same atmosphere but had no direct physical contact. The two half petri dishes were sealed together with Parafilm and then incubated in a dark chamber at 28 °C. The bottom of the petri dish containing the fungal lawn was inverted over a second petri dish bottom of identical size containing 1 ml suspension of mixed stage nematodes (about 300 nematodes). The attracted worms on the upper petri dish were counted after 2 days. Method 3: Volatile compounds bioassay: Diluted 6-MSA (in DMSO) was mixed with agar and added into 1 cm diameter circles in the test area. The same volume of solvent, DMSO was mixed with agar and added in the control area. More than 50 animals (synchronized young adult animals were washed three times in S-basal buffer) were placed at the center and allowed to move freely for 1 h, then 5 μl of 1 M sodium azide was added to each side to immobilize the worms, before counting. The chemotaxis index is the number of worms on the test area minus the number of worms on the solvent area divided by the sum of worms from both areas. Method 4: About 1 cm2 of PDA medium with the fungal colony of A. oryzae (transformed with empty vector) or the A. oryzae artA-expressing strain was placed in the test or control location of the Petri dish, opposite from each other. More than 50 synchronized young adult nematodes were directly added in the center of the plate. After 1.5 h, 5 μl of 1 M sodium azide was added to each side to immobilize the worms. The plates were further incubated for 0.5 h before the attracted worms on each side were counted. The paired test was applied for the analysis.
Statistics and reproducibility
Group sizes were based on previous experiments and are described in the figure legends or source materials. Unless specifically noted, each experiment was repeated three or more times independently. Data were collected from three biological and three technical replicates, unless otherwise noted. Data shown in column graphs or scatter plots represent mean ± the standard deviation (SD), as indicated in the figure legends. Plotted data points are shown. Statistical analysis was performed with ChemDraw Professional 15.1, GraphPad Prism 8.0.2, and OriginPro 2016. Details were given in the above methods and source data files.
Reporting summary
Further information on research design is available in the Nature Research Reporting Summary linked to this article.
Data availability
All data and strains are available from the authors upon request. All data generated or analyzed during this study are included in this published article (and its Supplementary Information files or source data file). The art genes correspond to the following loci in the Duddingtonia (Arthrobotrys) flagrans genome (BioProject number PRJNA494930): DFL_002601 (artA), DFL_002602 (artB), DFL_002603 (artC), DFL_002604 (artD), DFL_002606 (artE), DFL_002600 (artR). Source data are provided with this paper.
Change history
08 December 2021
A Correction to this paper has been published: https://doi.org/10.1038/s41467-021-27538-4
References
Yucel, G. & Small, S. Morphogens: precise outputs from a variable gradient. Curr. Biol. 16, R29–R31 (2006).
Tabata, T. & Takei, Y. Morphogens, their identification and regulation. Development 131, 703–712 (2004).
Etxebeste, O., Garzia, A., Espeso, E. A. & Ugalde, U. Aspergillus nidulans asexual development: making the most of cellular modules. Trends Microbiol. 18, 569–576 (2010).
Yu, Z. & Fischer, R. Light sensing and responses in fungi. Nat. Rev. Microbiol. 17, 25–36 (2019).
Champe, S. P. & El-Zayat, A. E. Isolation of a sexual sporulation hormone from Aspergillus nidulans. J. Bacteriol. 171, 3982–3988 (1989).
Champe, S. P., Rao, P. & Chang, A. An endogenous inducer of sexual development in Aspergillus nidulans. J. Gen. Microbiol. 133, 1383–1387 (1987).
Tsitsigiannis, D. I., Kowieski, T. M., Zarnowski, R. & Keller, N. P. Endogenous lipogenic regulators of spore balance in Aspergillus nidulans. Eukaryot. Cell 3, 1398–1411 (2004).
Tsitsigiannis, D. I., Kowieski, T. M., Zarnowski, R. & Keller, N. P. Three putative oxylipin biosynthetic genes integrate sexual and asexual development in Aspergillus nidulans. Microbiology 151, 1809–1821 (2005).
Hsueh, Y. P. et al. Nematophagous fungus Arthrobotrys oligospora mimics olfactory cues of sex and food to lure its nematode prey. eLife 6, e20023 (2017).
Hsueh, Y. P., Mahanti, P., Schroeder, F. C. & Sternberg, P. W. Nematode-trapping fungi eavesdrop on nematode pheromones. Curr. Biol. 23, 83–86 (2013).
Jiang, P. et al. The function of the three phosphoribosyl pyrophosphate synthetase (Prs) genes in hyphal growth and conidiation in Aspergillus nidulans. Microbiology 163, 1–15 (2017).
Vidal-Diez de Ulzurrun, G. & Hsueh, Y. P. Predator-prey interactions of nematode-trapping fungi and nematodes: both sides of the coin. Appl. Microbiol. Biotechnol. 102, 3939–3949 (2018).
Niu, X. M. & Zhang, K. Q. Arthrobotrys oligospora: a model organism for understanding the interaction between fungi and nematodes. Mycology 2, 59–78 (2011).
Jiang, X., Xiang, M. & Liu, X. Nematode-trapping fungi. Microbiol. Spectr. https://doi.org/10.1128/microbiolspec.FUNK-0022-2016 (2017).
Youssar, L. et al. Intercellular communication is required for trap formation in the nematode-trapping fungus Duddingtonia flagrans. PLoS Genet. 15, e1008029 (2019).
Wernet, V., Wäckerle, J. & Fischer, R. The STRIPAK component SipC is involved in morphology and cell-fate determination in the nematode-trapping fungus Duddingtonia flagrans. Genetics (in the press).
von Reuss, S. H. et al. Comparative metabolomics reveals biogenesis of ascarosides, a modular library of small-molecule signals in C. elegans. J. Am. Chem. Soc. 134, 1817–1824 (2012).
Ludewig, A. H. & Schroeder, F. C. Ascaroside signaling in C. elegans. WormBook https://doi.org/10.1895/wormbook.1.155.1 (2013).
Wang, X. et al. Bacteria can mobilize nematode-trapping fungi to kill nematodes. Nat. Commun. 5, 5776 (2014).
Zhang, H. X. et al. Morphology regulatory metabolites from Arthrobotrys oligospora. J. Nat. Prod. 75, 1419–1423 (2012).
Xu, Z. F. et al. High trap formation and low metabolite production by disruption of the polyketide synthase gene involved in the biosynthesis of arthrosporols from nematode-trapping fungus Arthrobotrys oligospora. J. Agric. Food Chem. 63, 9076–9082 (2015).
Chen, Y. H. et al. Novel polyketide-terpenoid hybrid metabolites and increased fungal nematocidal ability by disruption of genes 277 and 279 in nematode-trapping fungus Arthrobotrys oligospora. J. Agric. Food Chem. 68, 7870–7879 (2020).
He, Z. Q. et al. Sesquiterpenyl epoxy-cyclohexenoids and their signaling functions in nematode-trapping fungus Arthrobotrys oligospora. J. Agric. Food Chem. 67, 13061–13072 (2019).
da Silva, M. E. et al. Efficacy of Clonostachys rosea and Duddingtonia flagrans in reducing the haemonchus contortus infective larvae. Biomed. Res. Int. 2015, 474879 (2015).
Wenderoth, M. et al. Alternariol as virulence and colonization factor of Alternaria alternata during plant infection. Mol. Microbiol. 112, 131–146 (2019).
Xu, Z. F. et al. Nematicidal key precursors for the biosynthesis of morphological regulatory arthrosporols in the nematode-trapping fungus Arthrobotrys oligospora. J. Agric. Food Chem. 64, 7949–7956 (2016).
Bouwmeester, H., Schuurink, R. C., Bleeker, P. M. & Schiestl, F. The role of volatiles in plant communication. Plant J. 100, 892–907 (2019).
Pichersky, E., Noel, J. P. & Dudareva, N. Biosynthesis of plant volatiles: nature’s diversity and ingenuity. Science 311, 808–811 (2006).
Clavijo McCormick, A., Unsicker, S. B. & Gershenzon, J. The specificity of herbivore-induced plant volatiles in attracting herbivore enemies. Trends Plant Sci. 17, 303–310 (2012).
Kihika, R. et al. Parasitic nematode Meloidogyne incognita interactions with different Capsicum annum cultivars reveal the chemical constituents modulating root herbivory. Sci. Rep. 7, 2903 (2017).
Song, T. Y. et al. Potent nematicidal activity and new hybrid metabolite production by disruption of a cytochrome p450 gene involved in the biosynthesis of morphological regulatory arthrosporols in nematode-trapping fungus Arthrobotrys oligospora. J. Agric. Food Chem. 65, 4111–4120 (2017).
Hammerbacher, A., Coutinho, T. A. & Gershenzon, J. Roles of plant volatiles in defence against microbial pathogens and microbial exploitation of volatiles. Plant Cell Environ. 42, 2827–2843 (2019).
Lee, H. I., Leon, J. & Raskin, I. Biosynthesis and metabolism of salicylic acid. Proc. Natl Acad. Sci. USA 92, 4076–4079 (1995).
Yu, Z., Armant, O. & Fischer, R. Fungi use the SakA (HogA) pathway for phytochrome-dependent light signaling. Nat. Microbiol. 1, 16019 (2016).
Voss, B., Kirschhöfer, F., Brenner-Weiss, G. & Fischer, R. Alternaria alternata uses two siderophore systems for iron acquisition. Sci. Rep. 10, 3587 (2020).
Zhang, X., Noguez, J. H., Zhou, Y. & Butcher, R. A. Analysis of ascarosides from Caenorhabditis elegans using mass spectrometry and NMR spectroscopy. Methods Mol. Biol. 1068, 71–92 (2013).
Acknowledgements
X.H. was a fellow of the China Scholarship Council (CSC). F.K. and G.B.W. acknowledge support from the Helmholtz program BioInterfaces in Technology and Medicine (BIFTM) of KIT.
Funding
Open Access funding enabled and organized by Projekt DEAL.
Author information
Authors and Affiliations
Contributions
X.Y. performed most of the experiments. X.H. and M.M. contributed to the chemotaxis assays. N.W. developed the spatial expression analysis method. F.K., G.B.-W., J.S. and M.B. performed the metabolite analyses. R.F. supervised the project, provided most of the infrastructure, and wrote the manuscript.
Corresponding author
Ethics declarations
Competing interests
The authors declare no competing interests.
Additional information
Peer review information Nature Communications thanks Steven Harris and the other, anonymous, reviewers for their contribution to the peer review of this work.
Publisher’s note Springer Nature remains neutral with regard to jurisdictional claims in published maps and institutional affiliations.
Supplementary information
Source data
Rights and permissions
Open Access This article is licensed under a Creative Commons Attribution 4.0 International License, which permits use, sharing, adaptation, distribution and reproduction in any medium or format, as long as you give appropriate credit to the original author(s) and the source, provide a link to the Creative Commons license, and indicate if changes were made. The images or other third party material in this article are included in the article’s Creative Commons license, unless indicated otherwise in a credit line to the material. If material is not included in the article’s Creative Commons license and your intended use is not permitted by statutory regulation or exceeds the permitted use, you will need to obtain permission directly from the copyright holder. To view a copy of this license, visit http://creativecommons.org/licenses/by/4.0/.
About this article
Cite this article
Yu, X., Hu, X., Pop, M. et al. Fatal attraction of Caenorhabditis elegans to predatory fungi through 6-methyl-salicylic acid. Nat Commun 12, 5462 (2021). https://doi.org/10.1038/s41467-021-25535-1
Received:
Accepted:
Published:
Version of record:
DOI: https://doi.org/10.1038/s41467-021-25535-1
This article is cited by
-
GprC of the nematode-trapping fungus Arthrobotrys flagrans activates mitochondria and reprograms fungal cells for nematode hunting
Nature Microbiology (2024)
-
The cysteine-rich virulence factor NipA of Arthrobotrys flagrans interferes with cuticle integrity of Caenorhabditis elegans
Nature Communications (2024)
-
PKC-SWI6 signaling regulates asexual development, cell wall integrity, stress response, and lifestyle transition in the nematode-trapping fungus Arthrobotrys oligospora
Science China Life Sciences (2022)
-
Räuberische Pilze mit Anwendungspotenzial
BIOspektrum (2021)